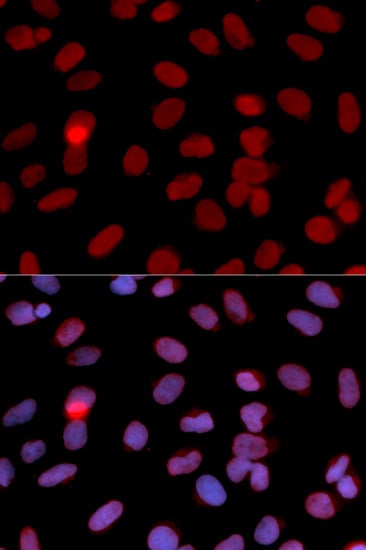
product-image-AAA305478_IF10.jpg
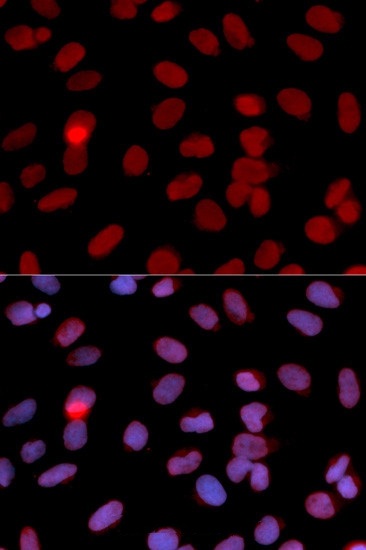
product-image-AAA167292_IF10.jpg

Replication protein A 32 kDa subunit (RPA2) Recombinant Protein | RPA2 recombinant protein
Recombinant Human Replication protein A 32 kDa subunit (RPA2), partial
Gene Names
RPA2; REPA2; RPA32; RP-A p32; RP-A p34
Purity
Greater or equal to 85% purity as determined by SDS-PAGE.
Synonyms
Replication protein A 32 kDa subunit (RPA2); N/A; Recombinant Human Replication protein A 32 kDa subunit (RPA2), partial; Replication factor A protein 2; RF-A protein 2; Replication protein A 34 kDa subunit; RP-A p34; RPA2 recombinant protein
Host
E Coli or Yeast or Baculovirus or Mammalian Cell
Purity/Purification
Greater or equal to 85% purity as determined by SDS-PAGE.
Form/Format
Lyophilized or liquid (Format to be determined during the manufacturing process)
Sequence Positions
1-267aa; Partial
Sequence
MWNSGFESYGSSSYGGAGGYTQSPGGFGSPAPSQAEKKSRARAQHIVPCTISQLLSATLVDEVFRIGNVEISQVTIVGIIRHAEKAPTNIVYKIDDMTAAPMDVRQWVDTDDTSSENTVVPPETYVKVAGHLRSFQNKKSLVAFKIMPLEDMNEFTTHILEVINAHMVLSKANSQPSAGRAPISNPGMSEAGNFGGNSFMPANGLTVAQNQVLNLIKACPRPEGLNFQDLKNQLKHMSVSSIKQAVDFLSNEGHIYSTVDDDHFKST
Preparation and Storage
Store at -20 degrees C. For long-term storage, store at -20 degrees C or -80 degrees C. Store working aliquots at 4 degrees C for up to one week. Repeated freezing and thawing is not recommended.
Related Product Information for RPA2 recombinant protein
As part of the heterotrimeric replication protein A complex (RPA/RP-A), binds and stabilizes single-stranded DNA intermediates, that form during DNA replication or upon DNA stress. It prevents their reannealing and in parallel, recruits and activates different proteins and complexes involved in DNA metabolism. Thereby, it plays an essential role both in DNA replication and the cellular response to DNA damage. In the cellular response to DNA damage, the RPA complex controls DNA repair and DNA damage checkpoint activation. Through recruitment of ATRIP activates the ATR kinase a master regulator of the DNA damage response. It is required for the recruitment of the DNA double-strand break repair factors RAD51 and RAD52 to chromatin in response to DNA damage. Also recruits to sites of DNA damage proteins like XPA and XPG that are involved in nucleotide excision repair and is required for this mechanism of DNA repair. Plays also a role in base excision repair (BER) probably through interaction with UNG. Through RFWD3 may activate CHEK1 and play a role in replication checkpoint control. Also recruits SMARCAL1/HARP, which is involved in replication fork restart, to sites of DNA damage. May also play a role in telomere maintenance
Product Categories/Family for RPA2 recombinant protein
References
The primary structure of the 32-kDa subunit of human replication protein A.Erdile L.F., Wold M.S., Kelly T.J.J. Biol. Chem. 265:3177-3182(1990) Cell-cycle-regulated phosphorylation of DNA replication factor A from human and yeast cells.Din S., Brill S.J., Fairman M.P., Stillman B.Genes Dev. 4:968-977(1990) cdc2 family kinases phosphorylate a human cell DNA replication factor, RPA, and activate DNA replication.Dutta A., Stillman B.EMBO J. 11:2189-2199(1992) The ionizing radiation-induced replication protein A phosphorylation response differs between ataxia telangiectasia and normal human cells.Liu V.F., Weaver D.T.Mol. Cell. Biol. 13:7222-7231(1993) Mammalian DNA nucleotide excision repair reconstituted with purified protein components.Aboussekhra A., Biggerstaff M., Shivji M.K., Vilpo J.A., Moncollin V., Podust V.N., Protic M., Huebscher U., Egly J.M., Wood R.D.Cell 80:859-868(1995) RPA involvement in the damage-recognition and incision steps of nucleotide excision repair.He Z., Henricksen L.A., Wold M.S., Ingles C.J.Nature 374:566-569(1995) Physical interaction between human RAD52 and RPA is required for homologous recombination in mammalian cells.Park M.S., Ludwig D.L., Stigger E., Lee S.H.J. Biol. Chem. 271:18996-19000(1996) Mapping of amino acid residues in the p34 subunit of human single-stranded DNA-binding protein phosphorylated by DNA-dependent protein kinase and Cdc2 kinase in vitro.Niu H., Erdjument-Bromage H., Pan Z.-Q., Lee S.-H., Tempst P., Hurwitz J.J. Biol. Chem. 272:12634-12641(1997) Sites of UV-induced phosphorylation of the p34 subunit of replication protein A from HeLa cells.Zernik-Kobak M., Vasunia K., Connelly M., Anderson C.W., Dixon K.J. Biol. Chem. 272:23896-23904(1997) The evolutionarily conserved zinc finger motif in the largest subunit of human replication protein A is required for DNA replication and mismatch repair but not for nucleotide excision repair.Lin Y.L., Shivji M.K., Chen C., Kolodner R., Wood R.D., Dutta A.J. Biol. Chem. 273:1453-1461(1998) Replication protein A stimulates long patch DNA base excision repair.De;Mott M.S., Zigman S., Bambara R.A.J. Biol. Chem. 273:27492-27498(1998) RBT1, a novel transcriptional co-activator, binds the second subunit of replication protein A.Cho J.M., Song D.J., Bergeron J., Benlimame N., Wold M.S., Alaoui-Jamali M.A.Nucleic Acids Res. 28:3478-3485(2000) ATR kinase activity regulates the intranuclear translocation of ATR and RPA following ionizing radiation.Barr S.M., Leung C.G., Chang E.E., Cimprich K.A.Curr. Biol. 13:1047-1051(2003) Coordinated regulation of replication protein A activities by its subunits p14 and p32.Weisshart K., Pestryakov P., Smith R.W.P., Hartmann H., Kremmer E., Lavrik O., Nasheuer H.-P.J. Biol. Chem. 279:35368-35376(2004) Mammalian TIMELESS and Tipin are evolutionarily conserved replication fork-associated factors.Gotter A.L., Suppa C., Emanuel B.S.J. Mol. Biol. 366:36-52(2007) RPA mediates recombination repair during replication stress and is displaced from DNA by checkpoint signalling in human cells.Sleeth K.M., Sorensen C.S., Issaeva N., Dziegielewski J., Bartek J., Helleday T.J. Mol. Biol. 373:38-47(2007) The human Tim/Tipin complex coordinates an Intra-S checkpoint response to UV that slows replication fork displacement.Uensal-Kacmaz K., Chastain P.D., Qu P.-P., Minoo P., Cordeiro-Stone M., Sancar A., Kaufmann W.K.Mol. Cell. Biol. 27:3131-3142(2007) Replication protein A prevents accumulation of single-stranded telomeric DNA in cells that use alternative lengthening of telomeres.Grudic A., Jul-Larsen A., Haring S.J., Wold M.S., Loenning P.E., Bjerkvig R., Boee S.O.Nucleic Acids Res. 35:7267-7278(2007) A quantitative atlas of mitotic phosphorylation.Dephoure N., Zhou C., Villen J., Beausoleil S.A., Bakalarski C.E., Elledge S.J., Gygi S.P.Proc. Natl. Acad. Sci. U.S.A. 105:10762-10767(2008) Lys-N and trypsin cover complementary parts of the phosphoproteome in a refined SCX-based approach.Gauci S., Helbig A.O., Slijper M., Krijgsveld J., Heck A.J., Mohammed S.Anal. Chem. 81:4493-4501(2009) The annealing helicase HARP is recruited to DNA repair sites via an interaction with RPA.Yusufzai T., Kong X., Yokomori K., Kadonaga J.T.Genes Dev. 23:2400-2404(2009) The annealing helicase SMARCAL1 maintains genome integrity at stalled replication forks.Bansbach C.E., Betous R., Lovejoy C.A., Glick G.G., Cortez D.Genes Dev. 23:2405-2414(2009) The SIOD disorder protein SMARCAL1 is an RPA-interacting protein involved in replication fork restart.Ciccia A., Bredemeyer A.L., Sowa M.E., Terret M.E., Jallepalli P.V., Harper J.W., Elledge S.J.Genes Dev. 23:2415-2425(2009) An alternative form of replication protein a prevents viral replication in vitro.Mason A.C., Haring S.J., Pryor J.M., Staloch C.A., Gan T.F., Wold M.S.J. Biol. Chem. 284:5324-5331(2009) An alternative form of replication protein a expressed in normal human tissues supports DNA repair.Kemp M.G., Mason A.C., Carreira A., Reardon J.T., Haring S.J., Borgstahl G.E., Kowalczykowski S.C., Sancar A., Wold M.S.J. Biol. Chem. 285:4788-4797(2010) A PP4 phosphatase complex dephosphorylates RPA2 to facilitate DNA repair via homologous recombination.Lee D.H., Pan Y., Kanner S., Sung P., Borowiec J.A., Chowdhury D.Nat. Struct. Mol. Biol. 17:365-372(2010) Quantitative phosphoproteomics reveals widespread full phosphorylation site occupancy during mitosis.Olsen J.V., Vermeulen M., Santamaria A., Kumar C., Miller M.L., Jensen L.J., Gnad F., Cox J., Jensen T.S., Nigg E.A., Brunak S., Mann M.Sci. Signal. 3:RA3-RA3(2010) Initial characterization of the human central proteome.Burkard T.R., Planyavsky M., Kaupe I., Breitwieser F.P., Buerckstuemmer T., Bennett K.L., Superti-Furga G., Colinge J.BMC Syst. Biol. 5:17-17(2011) E3 ligase RFWD3 participates in replication checkpoint control.Gong Z., Chen J.J. Biol. Chem. 286:22308-22313(2011) RING finger and WD repeat domain 3 (RFWD3) associates with replication protein A (RPA) and facilitates RPA-mediated DNA damage response.Liu S., Chu J., Yucer N., Leng M., Wang S.Y., Chen B.P., Hittelman W.N., Wang Y.J. Biol. Chem. 286:22314-22322(2011) DNA-PK-dependent RPA2 hyperphosphorylation facilitates DNA repair and suppresses sister chromatid exchange.Liaw H., Lee D., Myung K.PLoS ONE 6:E21424-E21424(2011) Translational regulation of RPA2 via internal ribosomal entry site and by eIF3a.Yin J.Y., Dong Z.Z., Liu R.Y., Chen J., Liu Z.Q., Zhang J.T.Carcinogenesis 34:1224-1231(2013) PRP19 transforms into a sensor of RPA-ssDNA after DNA damage and drives ATR activation via a ubiquitin-mediated circuitry.Marechal A., Li J.M., Ji X.Y., Wu C.S., Yazinski S.A., Nguyen H.D., Liu S., Jimenez A.E., Jin J., Zou L.Mol. Cell 53:235-246(2014) The crystal structure of the complex of replication protein A subunits RPA32 and RPA14 reveals a mechanism for single-stranded DNA binding.Bochkarev A., Bochkareva E., Frappier L., Edwards A.M.EMBO J. 18:4498-4504(1999) Structural basis for the recognition of DNA repair proteins UNG2, XPA, and RAD52 by replication factor RPA.Mer G., Bochkarev A., Gupta R., Bochkareva E., Frappier L., Ingles C.J., Edwards A.M., Chazin W.J.Cell 103:449-456(2000) Structure of the RPA trimerization core and its role in the multistep DNA-binding mechanism of RPA.Bochkareva E., Korolev S., Lees-Miller S.P., Bochkarev A.EMBO J. 21:1855-1863(2002)
NCBI and Uniprot Product Information
NCBI GI #
NCBI GeneID
NCBI Accession #
NCBI GenBank Nucleotide #
Molecular Weight
55.9 kDa
NCBI Official Full Name
replication protein A 32 kDa subunit isoform 2
NCBI Official Synonym Full Names
replication protein A2
NCBI Official Symbol
RPA2
NCBI Official Synonym Symbols
REPA2; RPA32; RP-A p32; RP-A p34
NCBI Protein Information
replication protein A 32 kDa subunit
UniProt Protein Name
Replication protein A 32 kDa subunit
UniProt Gene Name
RPA2
UniProt Synonym Gene Names
REPA2; RPA32; RPA34; RP-A p32; RF-A protein 2; RP-A p34
UniProt Entry Name
RFA2_HUMAN
Customer Reviews
Loading reviews...
Share Your Experience
Similar Products
Product Notes
The RPA2 rpa2 (Catalog #AAA81609) is a Recombinant Protein produced from E Coli or Yeast or Baculovirus or Mammalian Cell and is intended for research purposes only. The product is available for immediate purchase. The immunogen sequence is 1-267aa; Partial. The amino acid sequence is listed below: MWNSGFESYG SSSYGGAGGY TQSPGGFGSP APSQAEKKSR ARAQHIVPCT ISQLLSATLV DEVFRIGNVE ISQVTIVGII RHAEKAPTNI VYKIDDMTAA PMDVRQWVDT DDTSSENTVV PPETYVKVAG HLRSFQNKKS LVAFKIMPLE DMNEFTTHIL EVINAHMVLS KANSQPSAGR APISNPGMSE AGNFGGNSFM PANGLTVAQN QVLNLIKACP RPEGLNFQDL KNQLKHMSVS SIKQAVDFLS NEGHIYSTVD DDHFKST. It is sometimes possible for the material contained within the vial of "Replication protein A 32 kDa subunit (RPA2), Recombinant Protein" to become dispersed throughout the inside of the vial, particularly around the seal of said vial, during shipment and storage. We always suggest centrifuging these vials to consolidate all of the liquid away from the lid and to the bottom of the vial prior to opening. Please be advised that certain products may require dry ice for shipping and that, if this is the case, an additional dry ice fee may also be required.Precautions
All products in the AAA Biotech catalog are strictly for research-use only, and are absolutely not suitable for use in any sort of medical, therapeutic, prophylactic, in-vivo, or diagnostic capacity. By purchasing a product from AAA Biotech, you are explicitly certifying that said products will be properly tested and used in line with industry standard. AAA Biotech and its authorized distribution partners reserve the right to refuse to fulfill any order if we have any indication that a purchaser may be intending to use a product outside of our accepted criteria.Disclaimer
Though we do strive to guarantee the information represented in this datasheet, AAA Biotech cannot be held responsible for any oversights or imprecisions. AAA Biotech reserves the right to adjust any aspect of this datasheet at any time and without notice. It is the responsibility of the customer to inform AAA Biotech of any product performance issues observed or experienced within 30 days of receipt of said product. To see additional details on this or any of our other policies, please see our Terms & Conditions page.Item has been added to Shopping Cart
If you are ready to order, navigate to Shopping Cart and get ready to checkout.